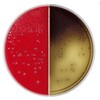
252500 BD BBL TM PEA�Y���A�l���R�����r�ARS���t���V�|�n/BBE���V�|�n 10�� �x�N�g���E�f�B�b�L���\�� 62619148

| |
| https://www.monotaro.com/p/6261/9148/ | 2026/06/02 13:25:09 |
| ベクトン・ディッキンソン BD BBL TM PEA添加アネロコロンビアRS血液寒天培地/BBE寒天培地 10枚 |
|
|
| 特長: | BDの新嫌気性菌用培地『アネロコロンビアRS血液寒天培地』に、フェニルエチルアルコールを添加し、大腸菌やプロテウスなどのグラム陰性菌の発育を阻止し、グラム陽性菌の選択に適した血液寒天培地です |
|---|---|
| 注意: | ※個人宅(戸建住宅・集合住宅)様への配送は行っておりません。 |
| 種類: | 寒天培地 |
| アズワン品番: | 63-6527-94 |
| 保管環境: | 冷蔵 |
特別運賃 この商品は個別に配送料が発生します。
| 地域 | 単位 | 配送費 |
|---|---|---|
| 全国 | 数量1につき | ¥500/税込¥550 |
| 北海道地方 | 数量1につき | ¥500/税込¥550 |
| 沖縄地方 | 数量1につき | ¥500/税込¥550 |
| 離島 | 数量1につき | ¥20,000/税込¥22,000 |
| Copyright 2000-2026 MonotaRO Co.,Ltd. All Rights Reserved. 株式会社MonotaRO(ものたろう) |